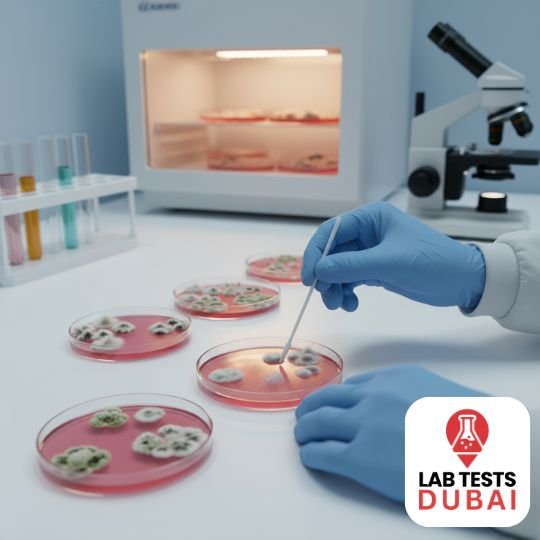

Fungal Culture/scalp Culture
249,00 د.إ
When an infection isn’t clearing or isn’t responding to standard antibiotics, a culture identifies exactly which bug is responsible and which antibiotic will work. It takes a day or two but prevents weeks of trial and error. Results 23-34 days. Home collection available anywhere in Dubai.
Description
What this test measures
This test cultures the bacteria from your sample, identifies the organism(s), and tests which antibiotics will kill them (sensitivity).
Who should take it
Anyone with a suspected bacterial infection that needs identification — typically after symptoms persist despite empirical antibiotics, or before starting treatment for a complicated infection.
How the test works
- Sample type: Blood
- Preparation: No fasting required unless your doctor advises otherwise.
- Methodology: Validated laboratory methodology
- Turnaround time: 23-34 days
- Where: Our Al Karama clinic or home collection anywhere in Dubai
What your results mean
Results report the organism(s) grown and the antibiotics they’re sensitive or resistant to. Your doctor uses this to choose the most effective treatment.
How to book
Book Fungal culture/scalp culture — AED 249
Frequently Asked Questions
How much does the Fungal culture/scalp culture test cost in Dubai?
AED 249, inclusive of 5% VAT and home collection within Dubai. No hidden fees.
How long do results take?
Results are typically available 23-34 days, delivered by email or WhatsApp.
Can I do this test at home?
Yes. Our trained phlebotomists can come to your home or office anywhere in Dubai. You can also visit our Al Karama clinic.
Do I need to fast?
No fasting required unless your doctor specifically advises it.

Reviews
There are no reviews yet.